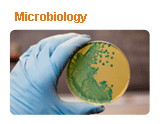
thumb-img-7

Complete Engineering Solutions
Sectors We Serve
Biss lab offers extensive range of testing services to cater numerous industry sector.
This is the heading
Lorem ipsum dolor sit amet, consectetur adipiscing elit. Ut elit tellus, luctus nec ullamcorper mattis, pulvinar dapibus leo.

About Us
Biss has successfully faced NABL Surveillance audit.BIS audit team approves that Biss fulfills the requirements for testing packaged drinking water.
Welcome to Biss Laboratories
Biss Laboratories Private Limited, an NABL accredited analytical laboratory, offers Biological, Chemical and Mechanical testing services along with Validations, Research and Failure investigations. Lucid provides reliable, affordable and accurate testing services as per international standards and specifications using well equipped facilities and state of the art instruments…
Each sample and each test requirement is unique. Whether it is classical analysis or the new age instrumentation we have the right mix of people adept to handle every requirement.
Biss labs as a company values integrity, personal excellence and continual improvement. Biss is committed to its customers and takes pride in serving them and striving for the highest quality. The senior management and the staff are independent, engaged, committed, and effective. Biss Management establishes, maintains, and monitors standards and policies for ethics, business practices, and compliance across the company.




